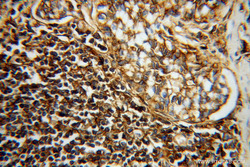

Antibody data
- Antibody Data
- Antigen structure
- References [44]
- Comments [0]
- Validations
- Western blot [1]
- Immunocytochemistry [1]
- Immunoprecipitation [1]
- Immunohistochemistry [2]
- Flow cytometry [1]
Submit
Validation data
Reference
Comment
Report error
- Product number
- 15240-1-AP - Provider product page

- Provider
- Proteintech Group
- Proper citation
- Proteintech Cat#15240-1-AP, RRID:AB_1557426
- Product name
- HLA class I ABC antibody
- Antibody type
- Polyclonal
- Description
- HLA class I ABC antibody (Cat. #15240-1-AP) is a rabbit polyclonal antibody that shows reactivity with human and has been validated for the following applications: FC, IF, IHC, IP, WB, ELISA.
- Reactivity
- Human
- Host
- Rabbit
- Conjugate
- Unconjugated
- Isotype
- IgG
- Vial size
- 20ul, 150ul
Submitted references MHC-I in the hippocampus promotes comorbid depressive symptoms in bone cancer pain via the upregulation of microglial TREM2/DAP12 signaling.
Proteogenomic analysis identifies neoantigens and bacterial peptides as immunotherapy targets in colorectal cancer.
Inhibition of the Eukaryotic Initiation Factor-2-α Kinase PERK Decreases Risk of Autoimmune Diabetes in Mice.
Construction of an ER stress-related prognostic signature for predicting prognosis and screening the effective anti-tumor drug in osteosarcoma.
G3BP1 and SLU7 Jointly Promote Immune Evasion by Downregulating MHC-I via PI3K/Akt Activation in Bladder Cancer.
SARS-CoV-2 ORF7a Mutation Found in BF.5 and BF.7 Sublineages Impacts Its Functions.
Circulating tumor cells shielded with extracellular vesicle-derived CD45 evade T cell attack to enable metastasis.
Hippo-signaling-controlled MHC class I antigen processing and presentation pathway potentiates antitumor immunity.
Clinically relevant humanized mouse models of metastatic prostate cancer to evaluate cancer therapies.
Genome-wide DNA methylation sequencing reveals epigenetic features and potential biomarkers of Sjögren syndrome.
The Toll-like Receptor 7-Mediated Ro52 Antigen-Presenting Pathway in the Salivary Gland Epithelial Cells of Sjögren's Syndrome.
Inhibition of FGFR3 upregulates MHC-I and PD-L1 via TLR3/NF-kB pathway in muscle-invasive bladder cancer.
SARS-CoV-2 accessory proteins ORF7a and ORF3a use distinct mechanisms to down-regulate MHC-I surface expression.
HIV-1 Nef Changes the Proteome of T Cells Extracellular Vesicles Depleting IFITMs and Other Antiviral Factors.
E3 ligase Trim35 inhibits LSD1 demethylase activity through K63-linked ubiquitination and enhances anti-tumor immunity in NSCLC.
Increased response to TPF chemotherapy promotes immune escape in hypopharyngeal squamous cell carcinoma.
Chemotherapy- and Immune-Related Gene Panel in Prognosis Prediction and Immune Microenvironment of SCLC.
Immunopeptidomics-based design of mRNA vaccine formulations against Listeria monocytogenes.
Self-Assembly of a Multifunction DNA Tetrahedron for Effective Delivery of Aptamer PL1 and Pcsk9 siRNA Potentiate Immune Checkpoint Therapy for Colorectal Cancer.
Sequential modulation of the Wnt/β-catenin signaling pathway enhances tumor-intrinsic MHC I expression and tumor clearance.
EZH2 Inhibitor Enhances the STING Agonist‒Induced Antitumor Immunity in Melanoma.
Peripheral Injection of Tim-3 Antibody Attenuates VSV Encephalitis by Enhancing MHC-I Presentation.
Immune infiltration profiling in gastric cancer and their clinical implications.
Targeting Pin1 renders pancreatic cancer eradicable by synergizing with immunochemotherapy.
Arecoline induces epithelial-mesenchymal transformation and promotes metastasis of oral cancer by SAA1 expression.
Cisplatin remodels the tumor immune microenvironment via the transcription factor EB in ovarian cancer.
Hepatitis C virus modulates signal peptide peptidase to alter host protein processing.
MYC suppresses STING-dependent innate immunity by transcriptionally upregulating DNMT1 in triple-negative breast cancer.
Repurposing screen identifies Amlodipine as an inducer of PD-L1 degradation and antitumor immunity.
THADA drives Golgi residency and upregulation of PD-L1 in cancer cells and provides promising target for immunotherapy.
Long Non-coding RNA LINC02195 as a Regulator of MHC I Molecules and Favorable Prognostic Marker for Head and Neck Squamous Cell Carcinoma.
Herpes Simplex Virus Type 2 Inhibits Type I IFN Signaling Mediated by the Novel E3 Ubiquitin Protein Ligase Activity of Viral Protein ICP22.
Noncoding RNA 886 alleviates tumor cellular immunological rejection in host C57BL/C mice.
Pancreatic beta cells persistently infected with coxsackievirus B4 are targets of NK cell-mediated cytolytic activity.
Inhibition of PCSK9 potentiates immune checkpoint therapy for cancer.
Down-regulation of the islet-specific zinc transporter-8 (ZnT8) protects human insulinoma cells against inflammatory stress.
An ARF6-Exportin-5 axis delivers pre-miRNA cargo to tumour microvesicles.
Activation of Toll-like receptor 7 signaling in labial salivary glands of primary Sjögren's syndrome patients.
Cytotoxic necrotizing factor 1 promotes prostate cancer progression through activating the Cdc42-PAK1 axis.
Loss of Fas expression and high expression of HLA-E promoting the immune escape of early colorectal cancer cells.
HIV-1 Nef: Taking Control of Protein Trafficking.
Nef neutralizes the ability of exosomes from CD4+ T cells to act as decoys during HIV-1 infection.
Using heterogeneity of the patient-derived xenograft model to identify the chemoresistant population in ovarian cancer.
The prognostic impact of human leukocyte antigen (HLA) class I antigen abnormalities in salivary gland cancer. A clinicopathological study of 288 cases.
Li X, Jia Y, Xiong M, Gao Y, Xu X, Ke C
Behavioural brain research 2024 Mar 12;461:114843
Behavioural brain research 2024 Mar 12;461:114843
Proteogenomic analysis identifies neoantigens and bacterial peptides as immunotherapy targets in colorectal cancer.
Yao P, Gao M, Hu W, Wang J, Wang Y, Wang Q, Ji J
Pharmacological research 2024 Jun;204:107209
Pharmacological research 2024 Jun;204:107209
Inhibition of the Eukaryotic Initiation Factor-2-α Kinase PERK Decreases Risk of Autoimmune Diabetes in Mice.
Muralidharan C, Huang F, Enriquez JR, Wang JE, Nelson JB, Nargis T, May SC, Chakraborty A, Figatner KT, Navitskaya S, Anderson CM, Calvo V, Surguladze D, Mulvihill MJ, Yi X, Sarkar S, Oakes SA, Webb-Robertson BM, Sims EK, Staschke KA, Eizirik DL, Nakayasu ES, Stokes ME, Tersey SA, Mirmira RG
bioRxiv : the preprint server for biology 2024 Jun 3;
bioRxiv : the preprint server for biology 2024 Jun 3;
Construction of an ER stress-related prognostic signature for predicting prognosis and screening the effective anti-tumor drug in osteosarcoma.
Chen W, Liao Y, Sun P, Tu J, Zou Y, Fang J, Chen Z, Li H, Chen J, Peng Y, Wen L, Xie X
Journal of translational medicine 2024 Jan 16;22(1):66
Journal of translational medicine 2024 Jan 16;22(1):66
G3BP1 and SLU7 Jointly Promote Immune Evasion by Downregulating MHC-I via PI3K/Akt Activation in Bladder Cancer.
Zheng X, Chen J, Deng M, Ning K, Peng Y, Liu Z, Li X, Zhou Z, Tang H, Li Y, Kang T, Liu Z
Advanced science (Weinheim, Baden-Wurttemberg, Germany) 2024 Feb;11(7):e2305922
Advanced science (Weinheim, Baden-Wurttemberg, Germany) 2024 Feb;11(7):e2305922
SARS-CoV-2 ORF7a Mutation Found in BF.5 and BF.7 Sublineages Impacts Its Functions.
Timilsina U, Ivey EB, Duffy S, Plianchaisuk A, The Genotype To Phenotype Japan G P-Japan Consortium, Ito J, Sato K, Stavrou S
International journal of molecular sciences 2024 Feb 16;25(4)
International journal of molecular sciences 2024 Feb 16;25(4)
Circulating tumor cells shielded with extracellular vesicle-derived CD45 evade T cell attack to enable metastasis.
Yang C, Wang X, To KKW, Cui C, Luo M, Wu S, Huang L, Fu K, Pan C, Liu Z, Fan T, Yang C, Wang F, Fu L
Signal transduction and targeted therapy 2024 Apr 5;9(1):84
Signal transduction and targeted therapy 2024 Apr 5;9(1):84
Hippo-signaling-controlled MHC class I antigen processing and presentation pathway potentiates antitumor immunity.
Peng L, Zhou L, Li H, Zhang X, Li S, Wang K, Yang M, Ma X, Zhang D, Xiang S, Duan Y, Wang T, Sun C, Wang C, Lu D, Qian M, Wang Z
Cell reports 2024 Apr 23;43(4):114003
Cell reports 2024 Apr 23;43(4):114003
Clinically relevant humanized mouse models of metastatic prostate cancer to evaluate cancer therapies.
Kostlan RJ, Phoenix JT, Budreika A, Ferrari MG, Khurana N, Cho JE, Juckette K, McCollum BL, Moskal R, Mannan R, Qiao Y, Griend DJV, Chinnaiyan AM, Kregel S
bioRxiv : the preprint server for biology 2023 Oct 17;
bioRxiv : the preprint server for biology 2023 Oct 17;
Genome-wide DNA methylation sequencing reveals epigenetic features and potential biomarkers of Sjögren syndrome.
Lu DQ, Yao XY, Ren YT, Zhang KY, Zhu XC, Hong T, Yu X, Xie ZM, Chen LY, Wang XC
International journal of rheumatic diseases 2023 Nov;26(11):2223-2232
International journal of rheumatic diseases 2023 Nov;26(11):2223-2232
The Toll-like Receptor 7-Mediated Ro52 Antigen-Presenting Pathway in the Salivary Gland Epithelial Cells of Sjögren's Syndrome.
Nishihata SY, Shimizu T, Umeda M, Furukawa K, Ohyama K, Kawakami A, Nakamura H
Journal of clinical medicine 2023 Jun 30;12(13)
Journal of clinical medicine 2023 Jun 30;12(13)
Inhibition of FGFR3 upregulates MHC-I and PD-L1 via TLR3/NF-kB pathway in muscle-invasive bladder cancer.
Wu W, Chen L, Jia G, Tang Q, Han B, Xia S, Jiang Q, Liu H
Cancer medicine 2023 Jul;12(14):15676-15690
Cancer medicine 2023 Jul;12(14):15676-15690
SARS-CoV-2 accessory proteins ORF7a and ORF3a use distinct mechanisms to down-regulate MHC-I surface expression.
Arshad N, Laurent-Rolle M, Ahmed WS, Hsu JC, Mitchell SM, Pawlak J, Sengupta D, Biswas KH, Cresswell P
Proceedings of the National Academy of Sciences of the United States of America 2023 Jan 3;120(1):e2208525120
Proceedings of the National Academy of Sciences of the United States of America 2023 Jan 3;120(1):e2208525120
HIV-1 Nef Changes the Proteome of T Cells Extracellular Vesicles Depleting IFITMs and Other Antiviral Factors.
da Silva-Januário ME, da Costa CS, Tavares LA, Oliveira AK, Januário YC, de Carvalho AN, Cassiano MHA, Rodrigues RL, Miller ME, Palameta S, Arns CW, Arruda E, Paes Leme AF, daSilva LLP
Molecular & cellular proteomics : MCP 2023 Dec;22(12):100676
Molecular & cellular proteomics : MCP 2023 Dec;22(12):100676
E3 ligase Trim35 inhibits LSD1 demethylase activity through K63-linked ubiquitination and enhances anti-tumor immunity in NSCLC.
Tang F, Lu C, He X, Lin W, Xie B, Gao X, Peng Y, Yang D, Sun L, Weng L
Cell reports 2023 Dec 26;42(12):113477
Cell reports 2023 Dec 26;42(12):113477
Increased response to TPF chemotherapy promotes immune escape in hypopharyngeal squamous cell carcinoma.
Li R, Yan L, Tian S, Zhao Y, Zhu Y, Wang X
Frontiers in pharmacology 2022;13:1097197
Frontiers in pharmacology 2022;13:1097197
Chemotherapy- and Immune-Related Gene Panel in Prognosis Prediction and Immune Microenvironment of SCLC.
Chen MY, Zeng YC, Zhao XH
Frontiers in cell and developmental biology 2022;10:893490
Frontiers in cell and developmental biology 2022;10:893490
Immunopeptidomics-based design of mRNA vaccine formulations against Listeria monocytogenes.
Mayer RL, Verbeke R, Asselman C, Aernout I, Gul A, Eggermont D, Boucher K, Thery F, Maia TM, Demol H, Gabriels R, Martens L, Bécavin C, De Smedt SC, Vandekerckhove B, Lentacker I, Impens F
Nature communications 2022 Oct 14;13(1):6075
Nature communications 2022 Oct 14;13(1):6075
Self-Assembly of a Multifunction DNA Tetrahedron for Effective Delivery of Aptamer PL1 and Pcsk9 siRNA Potentiate Immune Checkpoint Therapy for Colorectal Cancer.
Guo W, Gao H, Li H, Ge S, Zhang F, Wang L, Shi H, Han A
ACS applied materials & interfaces 2022 Jul 20;14(28):31634-31644
ACS applied materials & interfaces 2022 Jul 20;14(28):31634-31644
Sequential modulation of the Wnt/β-catenin signaling pathway enhances tumor-intrinsic MHC I expression and tumor clearance.
Dholakia J, Scalise CB, Katre AA, Goldsberry WN, Meza-Perez S, Randall TD, Norian LA, Novak L, Arend RC
Gynecologic oncology 2022 Jan;164(1):170-180
Gynecologic oncology 2022 Jan;164(1):170-180
EZH2 Inhibitor Enhances the STING Agonist‒Induced Antitumor Immunity in Melanoma.
Xu T, Dai J, Tang L, Yang L, Si L, Sheng X, Cui C, Chi Z, Kong Y, Guo J
The Journal of investigative dermatology 2022 Apr;142(4):1158-1170.e8
The Journal of investigative dermatology 2022 Apr;142(4):1158-1170.e8
Peripheral Injection of Tim-3 Antibody Attenuates VSV Encephalitis by Enhancing MHC-I Presentation.
Li G, Tang L, Hou C, Wang Z, Gao Y, Dou S, Mo R, Hao Y, Gao Z, Li Y, Dong J, Zhang J, Shen B, Wang R, Han G
Frontiers in immunology 2021;12:667478
Frontiers in immunology 2021;12:667478
Immune infiltration profiling in gastric cancer and their clinical implications.
Ren F, Zhao Q, Zhao M, Zhu S, Liu B, Bukhari I, Zhang K, Wu W, Fu Y, Yu Y, Tang Y, Zheng P, Mi Y
Cancer science 2021 Sep;112(9):3569-3584
Cancer science 2021 Sep;112(9):3569-3584
Targeting Pin1 renders pancreatic cancer eradicable by synergizing with immunochemotherapy.
Koikawa K, Kibe S, Suizu F, Sekino N, Kim N, Manz TD, Pinch BJ, Akshinthala D, Verma A, Gaglia G, Nezu Y, Ke S, Qiu C, Ohuchida K, Oda Y, Lee TH, Wegiel B, Clohessy JG, London N, Santagata S, Wulf GM, Hidalgo M, Muthuswamy SK, Nakamura M, Gray NS, Zhou XZ, Lu KP
Cell 2021 Sep 2;184(18):4753-4771.e27
Cell 2021 Sep 2;184(18):4753-4771.e27
Arecoline induces epithelial-mesenchymal transformation and promotes metastasis of oral cancer by SAA1 expression.
Ren H, He G, Lu Z, He Q, Li S, Huang Z, Chen Z, Cao C, Wang A
Cancer science 2021 Jun;112(6):2173-2184
Cancer science 2021 Jun;112(6):2173-2184
Cisplatin remodels the tumor immune microenvironment via the transcription factor EB in ovarian cancer.
Liu W, Wang Y, Xie Y, Dai T, Fan M, Li C, Zou Y
Cell death discovery 2021 Jun 5;7(1):136
Cell death discovery 2021 Jun 5;7(1):136
Hepatitis C virus modulates signal peptide peptidase to alter host protein processing.
Hirano J, Yoshio S, Sakai Y, Songling L, Suzuki T, Itoh Y, Zhang H, Chen DV, Haga S, Oomori H, Kodama T, Maeda Y, Ono Y, Takahashi Y, Standley DM, Yamamoto M, Moriishi K, Moriya K, Kanto T, Takehara T, Koike K, Matsuura Y, Okamoto T
Proceedings of the National Academy of Sciences of the United States of America 2021 Jun 1;118(22)
Proceedings of the National Academy of Sciences of the United States of America 2021 Jun 1;118(22)
MYC suppresses STING-dependent innate immunity by transcriptionally upregulating DNMT1 in triple-negative breast cancer.
Wu SY, Xiao Y, Wei JL, Xu XE, Jin X, Hu X, Li DQ, Jiang YZ, Shao ZM
Journal for immunotherapy of cancer 2021 Jul;9(7)
Journal for immunotherapy of cancer 2021 Jul;9(7)
Repurposing screen identifies Amlodipine as an inducer of PD-L1 degradation and antitumor immunity.
Li C, Yao H, Wang H, Fang JY, Xu J
Oncogene 2021 Feb;40(6):1128-1146
Oncogene 2021 Feb;40(6):1128-1146
THADA drives Golgi residency and upregulation of PD-L1 in cancer cells and provides promising target for immunotherapy.
Li C, Chi H, Deng S, Wang H, Yao H, Wang Y, Chen D, Guo X, Fang JY, He F, Xu J
Journal for immunotherapy of cancer 2021 Aug;9(8)
Journal for immunotherapy of cancer 2021 Aug;9(8)
Long Non-coding RNA LINC02195 as a Regulator of MHC I Molecules and Favorable Prognostic Marker for Head and Neck Squamous Cell Carcinoma.
Li H, Xiong HG, Xiao Y, Yang QC, Yang SC, Tang HC, Zhang WF, Sun ZJ
Frontiers in oncology 2020;10:615
Frontiers in oncology 2020;10:615
Herpes Simplex Virus Type 2 Inhibits Type I IFN Signaling Mediated by the Novel E3 Ubiquitin Protein Ligase Activity of Viral Protein ICP22.
Zhang M, Fu M, Li M, Hu H, Gong S, Hu Q
Journal of immunology (Baltimore, Md. : 1950) 2020 Sep 1;205(5):1281-1292
Journal of immunology (Baltimore, Md. : 1950) 2020 Sep 1;205(5):1281-1292
Noncoding RNA 886 alleviates tumor cellular immunological rejection in host C57BL/C mice.
Ma H, Wang M, Zhou Y, Yang JJ, Wang LY, Yang RH, Wen MJ, Kong L
Cancer medicine 2020 Jul;9(14):5258-5271
Cancer medicine 2020 Jul;9(14):5258-5271
Pancreatic beta cells persistently infected with coxsackievirus B4 are targets of NK cell-mediated cytolytic activity.
Nekoua MP, Bertin A, Sane F, Alidjinou EK, Lobert D, Trauet J, Hober C, Engelmann I, Moutairou K, Yessoufou A, Hober D
Cellular and molecular life sciences : CMLS 2020 Jan;77(1):179-194
Cellular and molecular life sciences : CMLS 2020 Jan;77(1):179-194
Inhibition of PCSK9 potentiates immune checkpoint therapy for cancer.
Liu X, Bao X, Hu M, Chang H, Jiao M, Cheng J, Xie L, Huang Q, Li F, Li CY
Nature 2020 Dec;588(7839):693-698
Nature 2020 Dec;588(7839):693-698
Down-regulation of the islet-specific zinc transporter-8 (ZnT8) protects human insulinoma cells against inflammatory stress.
Merriman C, Fu D
The Journal of biological chemistry 2019 Nov 8;294(45):16992-17006
The Journal of biological chemistry 2019 Nov 8;294(45):16992-17006
An ARF6-Exportin-5 axis delivers pre-miRNA cargo to tumour microvesicles.
Clancy JW, Zhang Y, Sheehan C, D'Souza-Schorey C
Nature cell biology 2019 Jul;21(7):856-866
Nature cell biology 2019 Jul;21(7):856-866
Activation of Toll-like receptor 7 signaling in labial salivary glands of primary Sjögren's syndrome patients.
Shimizu T, Nakamura H, Takatani A, Umeda M, Horai Y, Kurushima S, Michitsuji T, Nakashima Y, Kawakami A
Clinical and experimental immunology 2019 Apr;196(1):39-51
Clinical and experimental immunology 2019 Apr;196(1):39-51
Cytotoxic necrotizing factor 1 promotes prostate cancer progression through activating the Cdc42-PAK1 axis.
Guo Y, Zhang Z, Wei H, Wang J, Lv J, Zhang K, Keller ET, Yao Z, Wang Q
The Journal of pathology 2017 Oct;243(2):208-219
The Journal of pathology 2017 Oct;243(2):208-219
Loss of Fas expression and high expression of HLA-E promoting the immune escape of early colorectal cancer cells.
Huang R, Zhang D, Li F, Xiao Z, Wu M, Shi D, Xiang P, Bao Z
Oncology letters 2017 May;13(5):3379-3386
Oncology letters 2017 May;13(5):3379-3386
HIV-1 Nef: Taking Control of Protein Trafficking.
Pereira EA, daSilva LL
Traffic (Copenhagen, Denmark) 2016 Sep;17(9):976-96
Traffic (Copenhagen, Denmark) 2016 Sep;17(9):976-96
Nef neutralizes the ability of exosomes from CD4+ T cells to act as decoys during HIV-1 infection.
de Carvalho JV, de Castro RO, da Silva EZ, Silveira PP, da Silva-Januário ME, Arruda E, Jamur MC, Oliver C, Aguiar RS, daSilva LL
PloS one 2014;9(11):e113691
PloS one 2014;9(11):e113691
Using heterogeneity of the patient-derived xenograft model to identify the chemoresistant population in ovarian cancer.
Dobbin ZC, Katre AA, Steg AD, Erickson BK, Shah MM, Alvarez RD, Conner MG, Schneider D, Chen D, Landen CN
Oncotarget 2014 Sep 30;5(18):8750-64
Oncotarget 2014 Sep 30;5(18):8750-64
The prognostic impact of human leukocyte antigen (HLA) class I antigen abnormalities in salivary gland cancer. A clinicopathological study of 288 cases.
Müller M, Agaimy A, Zenk J, Ettl T, Iro H, Hartmann A, Seliger B, Schwarz S
Histopathology 2013 May;62(6):847-59
Histopathology 2013 May;62(6):847-59
No comments: Submit comment
Supportive validation
- Submitted by
- Proteintech Group (provider)
- Main image

- Experimental details
- HepG2 cells were subjected to SDS PAGE followed by western blot with 15240-1-AP(HLA class I (HLA-A) antibody) at dilution of 1:500
- Sample type
- cell line
Supportive validation
- Submitted by
- Proteintech Group (provider)
- Main image

- Experimental details
- Immunofluorescent analysis of HepG2 cells using 15240-1-AP( HLA class I (HLA-A) Antibody) at dilution of 1:25 and Rhodamine-Goat anti-Rabbit IgG
- Sample type
- cell line
Supportive validation
- Submitted by
- Proteintech Group (provider)
- Main image

- Experimental details
- IP Result of anti-HLA class I (HLA-A) (IP:15240-1-AP, 3ug; Detection:15240-1-AP 1:500) with HepG2 cells lysate 1720ug.
- Sample type
- cell line
Supportive validation
- Submitted by
- Proteintech Group (provider)
- Main image

- Experimental details
- Immunohistochemical of paraffin-embedded human stomach cancer using 15240-1-AP(HLA class I (HLA-A) antibody) at dilution of 1:100 (under 10x lens)
- Sample type
- tissue
- Submitted by
- Proteintech Group (provider)
- Main image
- Experimental details
- Immunohistochemical of paraffin-embedded human stomach cancer using 15240-1-AP(HLA class I (HLA-A) antibody) at dilution of 1:100 (under 40x lens)
- Sample type
- tissue
Supportive validation
- Submitted by
- Proteintech Group (provider)
- Main image

- Experimental details
- The HLA class I (HLA-A) antibody from Proteintech is a rabbit polyclonal antibody to a recombinant protein of human HLA class I (HLA-A). This antibody recognizes human antigen. The HLA class I (HLA-A) antibody has been validated for the following applications: ELISA, WB, IHC, IF, IP, FC analysis.